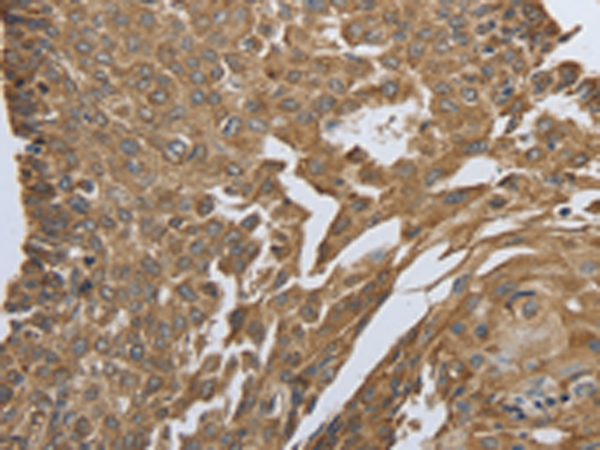

别名:AAT4, FAA4, SMHC, SMMHC应用:IHC
反应种属:Human, Mouse, Rat
规格:50μl/100μl
| Description |
|---|
| The protein encoded by this gene is a smooth muscle myosin belonging to the myosin heavy chain family. The gene product is a subunit of a hexameric protein that consists of two heavy chain subunits and two pairs of non-identical light chain subunits. It functions as a major contractile protein, converting chemical energy into mechanical energy through the hydrolysis of ATP. The gene encoding a human ortholog of rat NUDE1 is transcribed from the reverse strand of this gene, and its 3′ end overlaps with that of the latter. The pericentric inversion of chromosome 16 [inv(16)(p13q22)] produces a chimeric transcript that encodes a protein consisting of the first 165 residues from the N terminus of core-binding factor beta in a fusion with the C-terminal portion of the smooth muscle myosin heavy chain. This chromosomal rearrangement is associated with acute myeloid leukemia of the M4Eo subtype. Alternative splicing generates isoforms that are differentially expressed, with ratios changing during muscle cell maturation. Alternatively spliced transcript variants encoding different isoforms have been identified. |
| Specification | |
|---|---|
| Aliases | AAT4, FAA4, SMHC, SMMHC |
| Swissprot | P35749 |
| Host/Isotype | Rabbit IgG |
| Storage | Store at 4°C short term. Aliquot and store at -20°C long term. Avoid freeze/thaw cycles. |
| Species Reactivity | Human, Mouse, Rat |
| Immunogen | Synthetic peptide of human MYH11 |
| Formulation | pH7.4 PBS, 0.05% NaN3, 40% Glycerol |
| Application | |
|---|---|
| IHC | 1/50-1/200 |
| ELISA | 1/2000-1/10000 |
![]() |
The image is immunohistochemistry of paraffin-embedded Human brain tissue using P11122(MYH11 Antibody) at dilution 1/25. (Original magnification: ×200) |
![]() |
The image is immunohistochemistry of paraffin-embedded Human cervical cancer tissue using P11122(MYH11 Antibody) at dilution 1/25. (Original magnification: ×200) |
本公司的所有产品仅用于科学研究或者工业应用等非医疗目的,不可用于人类或动物的临床诊断或治疗,非药用,非食用。
暂无评论
本公司的所有产品仅用于科学研究或者工业应用等非医疗目的,不可用于人类或动物的临床诊断或治疗,非药用,非食用。
中文

发表回复